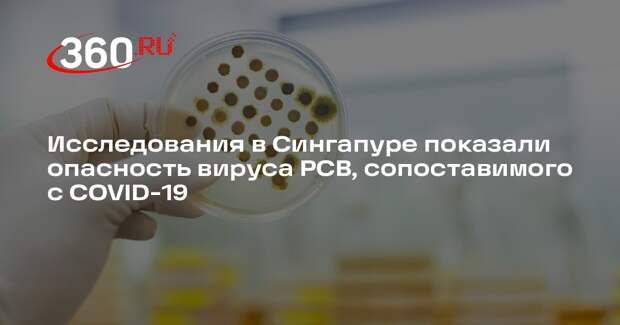

Респираторно-синцитиальный вирус (РСВ) может быть серьезным заболеванием в долгосрочной перспективе. Об этом говорит исследование, проведенные в Сингапурской больнице общего профиля, подробности опубликовали на сайте лечебного учреждения. «Ученые обнаружили, что это заболевание может быть сопоставимо по тяжести с другими, более известными респираторными вирусными инфекциями (РВИ), такими как грипп и COVID-19», — говорится в материале.
Ученые изучали тяжесть течения РСВ-инфекции, риск сердечных осложнений и долгосрочных последствий у пациентов, перенесших инфекцию в тяжелой форме в сравнении с пациентами, госпитализированными из-за гриппа и COVID-19. Во всех трех исследованиях специалисты установили, что РСВ-инфекция по тяжести течения сопоставима с этими двумя вирусами. Респираторно-синцитиальный вирус опасен, поскольку в некоторых случаях требует реанимационного лечения и имеет высокий показатель летального исхода, заявил врач и телеведущий Александр Мясников. По его словам, этот вирус является основной причиной бронхиолита и третьей по значимости причиной госпитализации из-за воспаления легких и нижних дыхательных путей.
Свежие комментарии